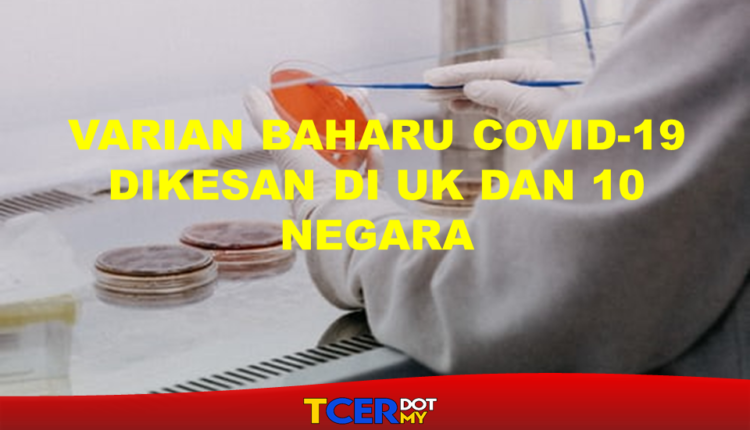

Varian Baharu Covid-19 Dikesan Di UK Dan 10 Negara
Varian Baharu Covid-19 Dikesan Di UK Dan 10 Negara Lain. Satu lagi varian Covid-19 (B.1.525) dikesan di United Kingdom (UK), serta 10 negara lain termasuk Amerika Syarikat (AS), lapor Agensi Berita Sputnik.
Menurut penyelidik University of Edinburgh dalam satu laporan pada Isnin, strain baharu telah ditemui melalui pengesanan genom di 11 negara: UK, Nigeria, Denmark, AS, Perancis, Belgium, Sepanyol, Kanada, Australia, Ghana, dan Jordan.
Denmark mencatatkan jumlah kes tertinggi B.1.525 sebanyak 35 kes, diikuti UK 33 kes, Nigeria 12 kes dan AS 10 kes manakala Perancis setakat ini melaporkan lima kes.
Rantaian terawal strain baharu Covid-19 itu dikesan pada Disember 2020 dengan kes pertama muncul di UK dan Nigeria.
VARIAN BAHARU COVID-19 MUNGKIN TIDAK TERKESAN DENGAN VAKSIN
Varian baharu itu dilihat lebih berdaya tahan terhadap antibodi. Menurut pakar UK, mereka sedang mengkaji dan memahami beberapa kesan risiko yang akan berlaku. Sehingga hari ini, varian tersebut masih dalam siasatan.
Profesor Ravi Gupta, dari Universiti Cambridge yang merupakan salah seorang saintis telah menasihatkan pemerintah tentang ancaman virus baharu ini.
Beliau berkata varian B.1.525 merupakan antara mutasi yang ketara daripada varian baharu covid-19 yang lain.
Apa yang menjadi perhatian sekarang ini dalah kemungkinan virus ini akan merebak dan tidak terkesan dengan vaksin Covid-19 B.1.525 atau disebut E484K akan menjadi ancaman terhadap reaksi vaksin.
Bagaimanapun, para saintis sedang mengkaji varian baru ini sebelum masuk musim sejuk.
Sumber : BERITA HARIAN
